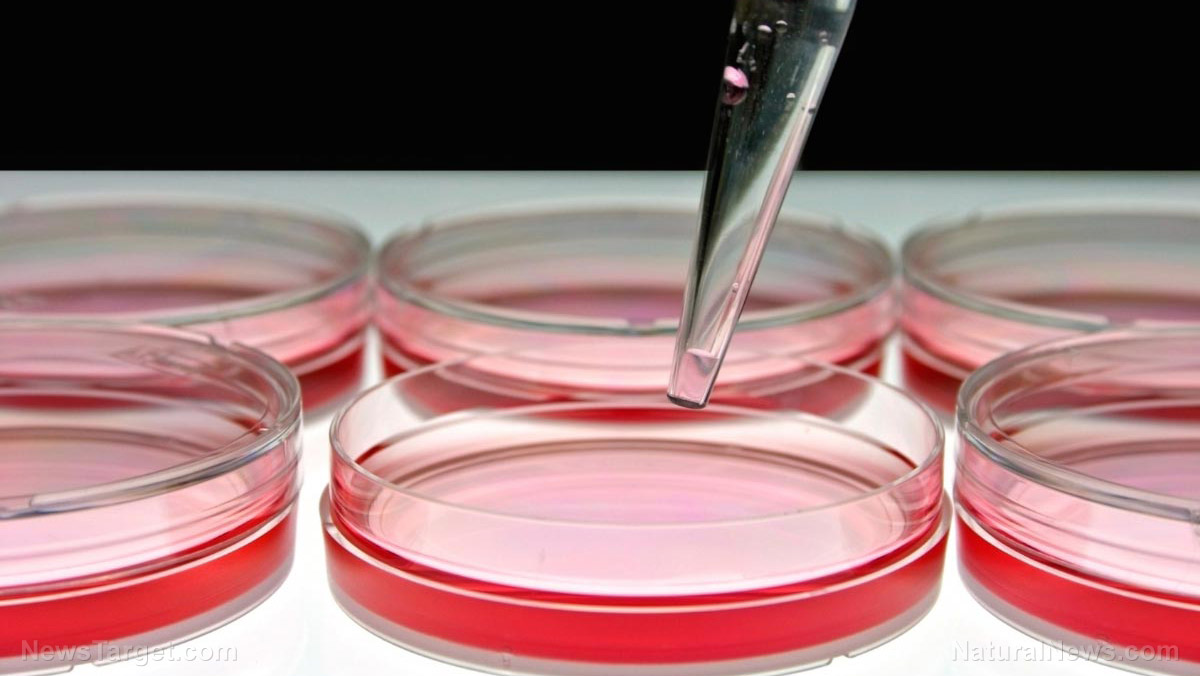

The many potential uses of fungi
Zamani is also working on creating superabsorbents from the cell walls of fungi that could be used for products like diapers and sanitary towels. The cell walls of fungus boast natural antibacterial properties, making them ideal for combating bacterial growth and unpleasant odors. They would be recyclable, and no oil would be needed to produce them. Professor of Bioprocess Technology Mohammad Taherzadeh has been working with an edible fungus known as Neurospora intermedia that can produce ethanol using waste and residue. He discovered this fungus’ potential 16 years ago, and he likens it to a Swiss army knife in the sense that it’s compact yet has many important uses. Edible fungus, he says, won’t hurt the environment, making it a great material to work with. The work being carried out by these researchers could address two big problems at once: food waste and the need for biodegradable and sustainable materials that won’t hurt the environment. Hopefully these projects will inspire others to find new ways to minimize our impact on the planet. Sources for this article include: HB.se HB.seWhat are some of the health benefits of quassia wood?
By Evangelyn Rodriguez // Share
Images from ESA’s spacecraft shows Nirgal Vallis, an ancient, dried-up river system on Mars
By Michael Alexander // Share
BOMBSHELL: Over 200 academics unwittingly assisting CCP military tech
By News Editors // Share
Evaluating the cytotoxicity of plant-derived phenolic compounds toward human carcinoma cells
By Evangelyn Rodriguez // Share
Researchers evaluate the antidiabetic activity of Mentha arvensis (wild mint)
By Evangelyn Rodriguez // Share
Handle with care: Why you need to wash fruits and veggies
By Rose Lidell // Share
Tai Chi could be the key to fighting age-related memory loss, reports study
By dominguez // Share
Scientists discover 63 new young asteroid families, doubling known count
By kevinhughes // Share
Trump’s alliance with Israel, NDAA powers, and political turmoil raise authoritarianism concerns
By finnheartley // Share
Pfizer deal and AI takeover: Trump’s final solution for American workforce?
By finnheartley // Share
21% of women in their 50s are addicted to ultra-processed foods, study finds
By isabelle // Share











